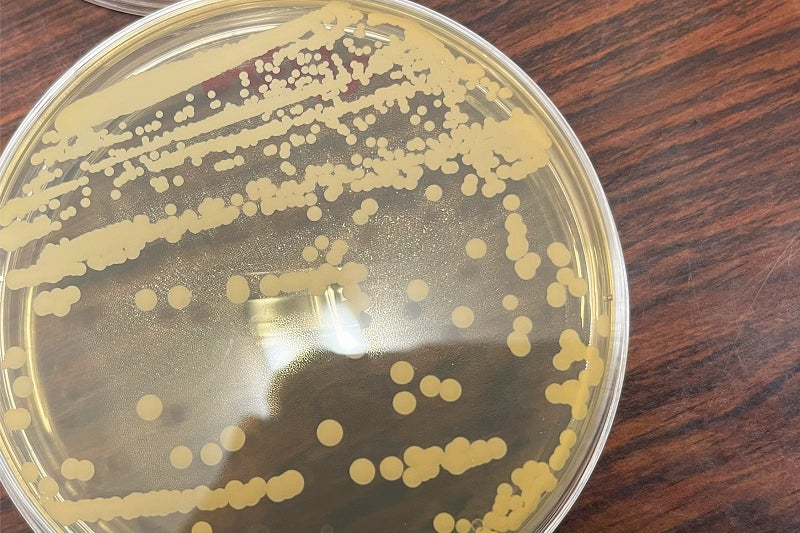

めざめよ、アカツキ。平六醸造、100年前の蔵付酵母を使用したクラフトサケ製造開始
限定醸造作品 Re:vive Origin アカツキ 8月下旬リリース、事前エントリー受付中

株式会社平六醸造(岩手県紫波町 代表取締役平井佑樹、以下当社)は地方独立行政法人岩手県工業技術センターとの共同研究によって旧造り蔵から発見された蔵付清酒酵母「アカツキ」を使用したクラフトサケ醸造を開始した。当社が醸造所を構える国指定重要文化財「日詰平井邸」には、かつて大正末期まで家業として醸造が営まれていた造り蔵(1909完成)が現存しており、奇跡的に当時の清酒酵母が発見された。オリジナル酵母を使用したクラフトサケ製造によって、より個性の強い地域に根差した商品づくりに期待される。初回醸造は限定商品「Re:vive Origin アカツキ」として今年8月下旬に発売予定。

一株の酵母との出会い
2023年春、当社は(地独)岩手県工業技術センターと日本酒製法をベースとした新ジャンル・クラフトサケのレシピ開発に向け共同研究契約を締結しました。試験醸造や酒質設計においてはもちろんのこと、酒造の世界観を表現するうえで大きな役割を持つ酵母。日本醸造協会から頒布される「協会酵母」や都道府県で独自に開発された酵母を使うことが一般的であり、酵母の種類によって香りの成分や発酵力に個性があり、仕上がりの香味に大きな影響を及ぼします。
紫波の豊かな風土や日詰平井邸に流れる穏やかな時間を伝える当社のクラフトサケにおいて、地元産原材料は重要なものです。さらにそれを色濃く、解像度を高めていくために酵母の発見は共同研究の念願でした。

醸造所の設備工事が始まる直前の2023年6月、造り蔵の天井、梁、柱、壁など至る所から200本以上のサンプルを採取。綿棒で擦り培養液に保存し持ち帰り、培地に拡大培養を繰り返す途方もない地道な作業でした。本当に存在するかも分からない酵母を無数の菌の中から探し出す作業にご協力いただいた同センターの先生方には心から感謝しております。
そして奇跡的に発見された一株の清酒酵母。
分析の結果、
① 清酒酵母(Saccharomyces cerevisiae)であること
② 泡あり酵母であること
③ アルコール発酵能があること
④ 協会酵母でないこと
⑤ 岩手県酵母でないこと
⑥ その他の頒布実績ある酵母でないこと
以上のことから、100年前に家業として醸造が営まれた時代に蔵に棲み付いた酵母である可能性が極めて高いことを確認いたしました。さらに小規模な試験醸造にて香気成分やアルコール耐性、生成する酸度などに問題がなく実用に資することが分かり、2024年共同研究契約を更新し、実地醸造に向けた試験醸造を継続しておりました。
100年の眠りからのめざめ
当社の仕込配合や環境に合わせた試験醸造を繰り返し、現場での再現性が高いことを確認。いよいよ7月より日詰平井邸にて実地醸造を開始いたしました。

初回醸造作品は「Re:vive Origin」と名付け、限定商品として2024年8月下旬に発売予定。
コンセプトは「彼の地へ馳せて」。100年眠り続けてきた酵母が見せる或る日の情景を紫波特産もち発芽玄米を含む5種の原料米で手間と費用を惜しまず丁寧に醸造し表現します。
100年の眠りから目覚めた蔵付酵母、アカツキ
かつて家業として醸造が営まれていた造り蔵に息をひそめ、およそ一世紀もの間眠り続けてきた酵母・アカツキ。2023年、醸造所工事前に採取した200本以上のサンプルから奇跡的に発見されました。強靭な発酵能力を持ち、持ち味である超濃厚かつ超低温の吟醸造りをより高いレベルで実現します。現在使われているどの酵母とも異なるテクスチャを持ち、紫波・平六醸造でこそ造り得る唯一無二の味わいを。

168+72時間で仕立てる発芽玄米麹
紫波町特産もち米の発芽玄米麹は平六醸造のお酒にとって生命線ともいえる重要な原料です。およそ一週間の浸漬期間を経て発芽した玄米を麹にし、醸造用乳酸を使用せず、既存の生酛系酒母にも分類されないオリジナルの製法によって酒母を仕込みます。製麹には通常の1.5倍の時間をかけ、水分量と品温を注視しながら仕上げていきます。発芽玄米に含まれている豊富な栄養分が過酷な環境で発酵する酵母を助け、香りと味わいを最大限引き出します。

設えた5種の原料米
一般的な清酒製造においては1~2種の原料米を使用することが多いことに比べ、目的に合わせて個別に5種の原料米を使用しています。発芽玄米「ヒメノモチ」にはじまり、酒母用掛米は栄養豊富な一般品種を低精白で、麹用米は糖化酵素を引き出し清楚な味わいに仕上げる吟醸精米。もろみの大半を占める掛米は大吟醸クラスの高精白を使用。すべては造り得る最高の酒を求めて、手間もコストも顧みず挑戦する意欲作です。

ありのままに彩られた、新故融合の香り
やわらかく搾り落された滴は、ありのままの柔らかな光沢を放つ。和梨や甜瓜を想わせる果実香と穀物のようなニュアンスが調和し、どこか懐かしくも、モダンな洗練された香りが感じられます。口になめらかに滑り込むと、白桃のような甘味を膨らませながら、涼しげな酸味と小気味よい苦味が交互に弾けます。終盤に掛けてそれらはボリュームを増し、ノスタルジックな余韻を残しながら清楚に流れ消えていきます。
事前エントリー受付中
現在、順調に発酵は進んでおり「Re:vive Origin アカツキ」は2024年8月下旬リリースに向けて準備を進めております。公式WEBでは事前エントリーを受付中。事前登録者は一般販売に優先して購入のお申込みが可能です。
▼商品詳細
商品名 Re:vive Origin アカツキ 2024
製造者 株式会社平六醸造
岩手県紫波郡紫波町日詰字郡山駅246番地
醸造者 平井佑樹
原料⽶ 「ヒメノモチ」発芽玄米
「あきたこまち」精米歩合80%(酛掛米)
「ぎんおとめ」精米歩合50%(麹用)
「ぎんおとめ」精米歩合40%(掛米)
「ヒメノモチ」精米歩合90%(掛米)
※原料米は全て岩手県産、契約栽培米
アルコール分 14度
酵 母 アカツキ
火 入 なし(生酒)
割 水 なし(原酒)
ろ 過 なし(無濾過)
内容量 720ml
価 格 11,000 円(税込)
※送料無料
※専用化粧箱入
※お一人様2本まで
※2024年8月下旬出荷開始予定

100年のめざめを一人でも多くの人と
平六醸造は創業以前より多くのみなさまに応援され、100年の時が流れる国指定重要文化財・日詰平井邸の造り蔵を新たな時代を歩むクラフトサケ醸造所として現代によみがえらせることができました。そして、初出荷を迎えた2024年2月から現在まで、地元はもちろんのこと全国各地の日本酒愛飲家のみなさまに作品をお楽しみいただいております。アカツキとの奇跡的な出会いと間もなく迎える新たな夜明けの瞬間をみなさまと迎えたいと切に願っております。
このプレスリリースには、メディア関係者向けの情報があります
メディアユーザー登録を行うと、企業担当者の連絡先や、イベント・記者会見の情報など様々な特記情報を閲覧できます。※内容はプレスリリースにより異なります。
すべての画像
- 種類
- 商品サービス
- ビジネスカテゴリ
- ソフトドリンク・アルコール飲料
- ダウンロード
